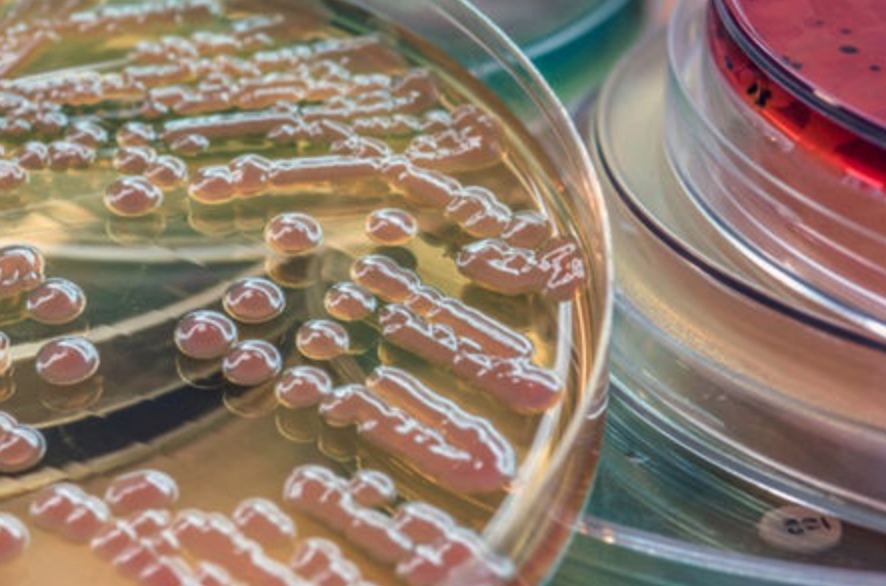

Enzymatic Digest of Animal Tissue is a Powdered Peptic Digest of Animal Tissue (Peptone A).
Enzymatic Digest of Animal Tissue
-
Product Applications: Food safety testing, Listeria pre-enrichment media,
Product Class: Meat extract,
Product Category: Microbiology & BioPharma
Product Applications: Food safety testing, Listeria pre-enrichment media,
Product Class: Meat extract,
Product Category: Microbiology & BioPharma
Enzymatic Digest of Animal Tissue
Product Information
Enzymatic Digest of Animal Tissue is a Powdered Peptic Digest of Animal Tissue (Peptone A). It is used in Food Safety Testing, Listeria pre-enrichment media such as Fraser Broth and Campylobacter Selective media.